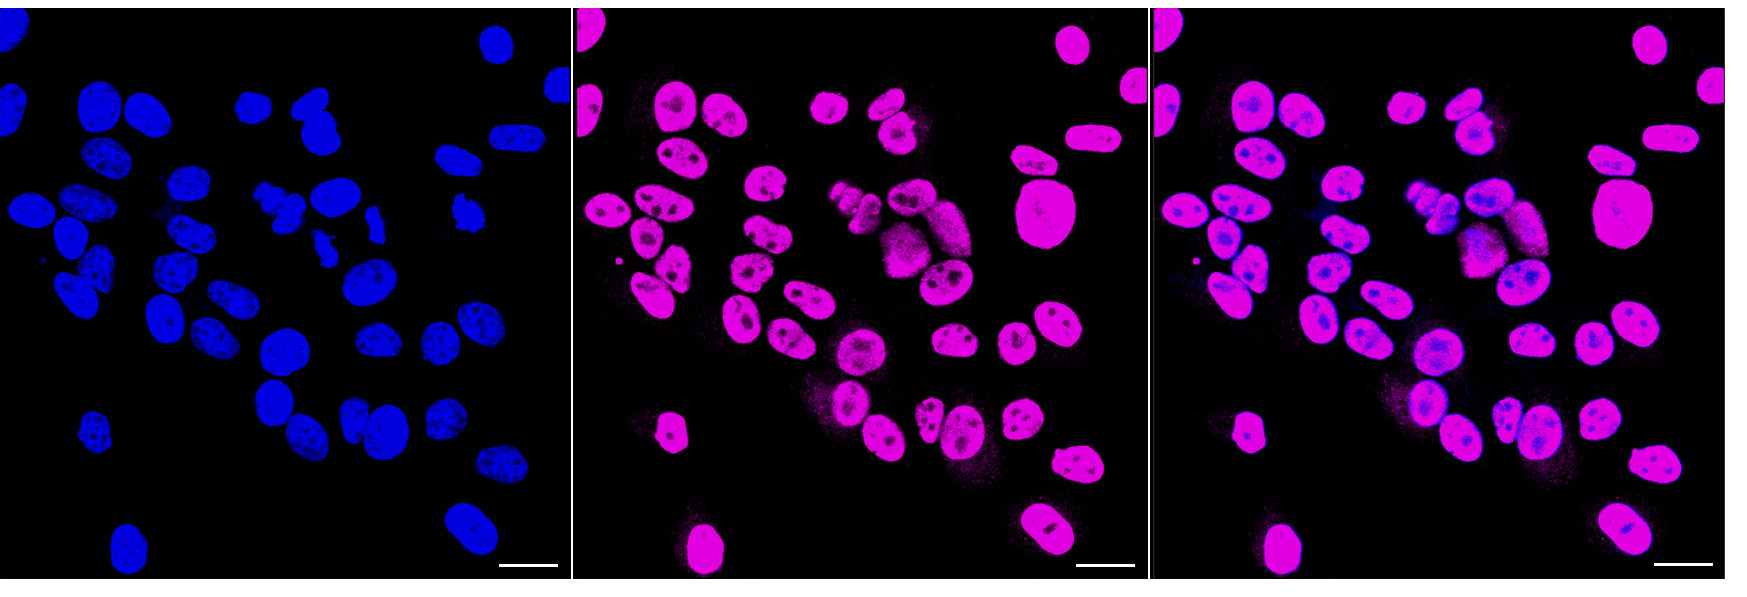

-
中文名稱:STAT1 Recombinant Monoclonal Antibody
-
貨號:CSB-RA249171A0HU
-
規格:¥1320
-
圖片:
-
Flow cytometric analysis of phospho-STAT1 (S727) expression in HepG2 cells using phospho-STAT1 (S727) antibody. Green, isotype control; red, phospho-STAT1 (S727).
-
Immunocytochemical staining of HepG2 cells with phospho-STAT1 (S727) antibody. Nuclei were stained blue with DAPI; Phospho-STAT1 (S727) was stained magenta with Alexa Fluor? 647. Images were taken using Leica stellaris 5. Protein abundance based on laser Intensity and smart gain: High. Scale bar, 20 μm.
-
Western blotting analysis using phospho-STAT1 (S727) antibody. Total cell lysates (30 μg) from various cell lines were loaded and separated by SDS-PAGE. The blot was incubated with phospho-STAT1 (S727) antibody and HRP-conjugated goat anti-rabbit secondary antibody respectively.
-
-
其他:
產品詳情
-
Uniprot No.:
-
基因名:
-
別名:STAT1; Signal Transducer And Activator Of Transcription 1; Transcription Factor ISGF-3 Components P91/P84; STAT91; ISGF-3; Signal Transducer And Activator Of Transcription 1-Alpha/Beta; Signal Transducer And Activator Of Transcription 1, 91kDa; Signal Transducer And Activator Of Transcription 1, 91kD; CANDF7; IMD31A; IMD31B; IMD31C
-
反應種屬:Human, Mouse, Rat
-
免疫原:A synthesized peptide derived from Human STAT1 protein
-
免疫原種屬:Homo sapiens (Human)
-
標記方式:Non-conjugated
-
克隆類型:Monoclonal
-
抗體亞型:Rabbit IgG
-
純化方式:Affinity-chromatography
-
克隆號:16E9
-
濃度:It differs from different batches. Please contact us to confirm it.
-
保存緩沖液:Rabbit IgG in PBS (pH 7.4) containing 50% glycerol, and 0.02% sodium azide.
-
產品提供形式:Liquid
-
應用范圍:ELISA, WB, FC, ICC
-
推薦稀釋比:
Application Recommended Dilution WB 1:1000-1:5000 FC 1:200-1:2000 ICC 1:100-1:1000 -
Protocols:
-
儲存條件:Upon receipt, store at -20°C or -80°C. Avoid repeated freeze.
-
貨期:Basically, we can dispatch the products out in 1-3 working days after receiving your orders. Delivery time maybe differs from different purchasing way or location, please kindly consult your local distributors for specific delivery time.
-
用途:For Research Use Only. Not for use in diagnostic or therapeutic procedures.
相關產品
靶點詳情
-
功能:Signal transducer and transcription activator that mediates cellular responses to interferons (IFNs), cytokine KITLG/SCF and other cytokines and other growth factors. Following type I IFN (IFN-alpha and IFN-beta) binding to cell surface receptors, signaling via protein kinases leads to activation of Jak kinases (TYK2 and JAK1) and to tyrosine phosphorylation of STAT1 and STAT2. The phosphorylated STATs dimerize and associate with ISGF3G/IRF-9 to form a complex termed ISGF3 transcription factor, that enters the nucleus. ISGF3 binds to the IFN stimulated response element (ISRE) to activate the transcription of IFN-stimulated genes (ISG), which drive the cell in an antiviral state. In response to type II IFN (IFN-gamma), STAT1 is tyrosine- and serine-phosphorylated. It then forms a homodimer termed IFN-gamma-activated factor (GAF), migrates into the nucleus and binds to the IFN gamma activated sequence (GAS) to drive the expression of the target genes, inducing a cellular antiviral state. Becomes activated in response to KITLG/SCF and KIT signaling. May mediate cellular responses to activated FGFR1, FGFR2, FGFR3 and FGFR4.
-
基因功能參考文獻:
- we suggest that STAT1HDAC4 signaling induces malignant tumor features such as EMT and sphere formation in CUG2overexpressing cancer cells. PMID: 30226605
- Downregulated NDR1 protein kinase inhibits innate immune response by initiating an miR146a-STAT1 feedback loop. PMID: 30018336
- High STAT1 expression is associated with Melanoma. PMID: 29150430
- These results demonstrated that the IFNGinduced immunosuppressive properties of B7H1 in human BM and WJMSCs were mediated by STAT1 signaling, and not by PI3K/RACalpha serine/threonineprotein kinase signaling PMID: 29901104
- STAT1 plays a pivotal role as a tumor suppressor in glioma. PMID: 29800921
- the present study revealed a negative correlation between the expression of the STAT-1 gene and the glioma grade, as well as between STAT-1 and mutant p53 expression. The negative correlation between STAT-1 and the pathological level of glioma suggested that STAT-1 may be associated with the occurrence and development of glioma, and may be a diagnostic biomarker and therapeutic target for the malignancy of glioma. PMID: 29620180
- PARP9 and PARP14 regulate macrophage activation in macrophage cell lines treated with either IFNgamma or IL-4; PARP14 silencing induces pro-inflammatory genes and STAT1 phosphorylation in M(IFNgamma) cells, whereas it suppresses anti-inflammatory gene expression and STAT6 phosphorylation in M(IL-4) cells PMID: 27796300
- PVT1 interacts with STAT1 to inhibit IFN-alpha signaling and tumor cells proliferation. PMID: 29715456
- STAT1 is associated with giant cell tumor of bone recurrence, which might serve as biomarker for giant cell tumor of bone recurrence PMID: 29651441
- High STAT1 expression is associated with head and neck squamous cell carcinoma. PMID: 29328389
- The research described here specifies where in the JAK/STAT signaling cascade the IFN response is inhibited and which protein domain of nsP2 is responsible for IFN inhibition. The results illuminate new aspects of antiviral defense and CHIKV counterdefense strategies and will direct the search for novel antiviral compounds. PMID: 29925658
- These results reveal that STAT1 pS727 regulates growth and differentiation in JAK-STAT activated neoplasms and suggest that Mediator kinase inhibition represents a therapeutic strategy to regulate JAK-STAT signaling PMID: 29239838
- Transcription factor STAT1 regulates the expression of LINC00174 PMID: 29729381
- Dysregulation of the IFN-gamma-STAT1 signaling pathway in a cell line model of large granular lymphocyte leukemia PMID: 29474442
- STAT1b plays a key role in enhancing the tumor suppressor function of STAT1a, in ESCC, in a manner that can be amplified by IFN-gamma PMID: 28981100
- HSP90 is an upstream regulator of the ACK1-dependent phosphorylation of STAT1 and STAT3. PMID: 28739485
- These findings suggest that IFN-a can inhibit HCV replication through a STAT2-dependent but STAT1-independent pathway, whereas IFN-g induces ISG expression and inhibits HCV replication exclusively through a STAT1- and STAT2-dependent pathway. PMID: 27929099
- MxA inhibits hepatitis C virus replication through JAK-STAT pathway activation. PMID: 29417241
- These results indicate the potential involvement of STAT1 in the regulation of trophoblast behavior. Furthermore, STAT 1 functions are more efficiently inhibited by blocking its expression than its phosphorylation. PMID: 28552376
- Authors detected the ERK, p-ERK and STAT1 expression in 131 ESCC cases and 22 case-matched normal esophageal tissues adjacent to the tumors specimens. These findings provide pathological evidence that ERK/p-ERK is negatively correlated with STAT1 in ESCC. PMID: 28431406
- 129:Stat1 (-/-) is a unique model for studying the critical origins and risk reduction strategies in age-related ER(+) breast cancer. In addition, it can be used in preclinical trials of hormonal and targeted therapies as well as immunotherapies. PMID: 28865492
- STAT1 knockdown using an inhibitor and siRNA attenuated the IL-17-mediated increases in IL-6, IL-8 and VEGF expression in A549 and H292 cells. PMID: 27819281
- Review of the role of STAT1 and STAT3 gain-of-function mutations in primary immunodeficiency/immunodysregulation disorders. PMID: 28914637
- IFN gamma induced upregulation of BCL6 was dependent on the classical STAT1 signaling pathway, and affected both major BCL6 variants. Interestingly, although IFN alpha induced stronger STAT1 phosphorylation than IFN gamma, it only slightly upregulated BCL6 in multiple myeloma lines. PMID: 29510136
- this study shows that miR-146a negatively regulates NK cell functions via STAT1 signaling PMID: 26996068
- Authors found that YY1 and STAT1 were upregulated in ox-LDL-stimulating macrophages followed by translocation in the nucleus and binding to the transcriptional promoter region of miR-29a, thus leading to the increase of miR-29a expression. PMID: 28593745
- Candidate biomarker genes such as CXCL10, IRF1, STAT1, IFIT2, and IFIT3 may be suitable therapeutic targets for ICM. PMID: 28150292
- Aberrant Th1 immune responses in biliary atresia promote the proliferation and secretion of hepatic stellate cells through the IFN-gamma/STAT1 pathway. PMID: 28304404
- Calcitriol treatment of the TL-1 cell line (model of T-LGLL) led to decreased phospho-Y701 STAT1 and phospho-Y705 STAT3 and increased vitamin D receptor (VDR) levels. PMID: 27715403
- These findings indicate that viral replication and inflammation are linked through a common IFNgamma-like, STAT-dependent pathway and that HIV-1-induced STAT1 and STAT3 signaling are involved in both inflammation and HIV-1 replication. PMID: 28142265
- Increased levels of STAT1 Protein in CD4 T-cells from systemic lupus erythematosus patients are associated with disease severity. PMID: 28256939
- miR203 acts as a tumor suppressor in glioblastoma by suppressing the pro-tumorigenic action of STAT1. PMID: 27705947
- Results show that high ph-STAT1 and ph-STAT3 tumor cell expression were associated with increased ER and PR, reduced tumor grade and necrosis. STAT1 and STAT3 expression appeared to be an important determinant of favorable outcome in patients with invasive ductal breast cancer suggesting that both act as tumor suppressor proteins in patients with ductal breast cancer. PMID: 27769057
- Results identified STAT1 as a central node of tumor-stimulated stromal signature and demonstrate that stromal STAT1 expression promotes tumor progression. PMID: 28108623
- The results of the present study indicate that ISTP may inhibit TARC/CCL17 production in human epidermal keratinocytes via the STAT1 signaling pathway and may be associated with the inhibition of IL33 production. PMID: 28447741
- In human gastrointestinal stromal tumors (GIST) cell lines, treatment with imatinib abrogated the IFNgamma-induced upregulation of PD-L1 via STAT1 inhibition. PD-1/PD-L1 blockade is a promising strategy to improve the effects of targeted therapy in GISTs PMID: 27470968
- STAT3/STAT1 ratios are better clinical predictors in colorectal carcinoma as compared to STAT3 or STAT1 levels alone. PMID: 27191495
- In a subgroup of Schizophrenic patients, blood levels of STAT1 were significantly higher compared to the control group. PMID: 27820940
- Suggest a positive feedback mechanism via the STAT1/3 pathway sustains cytokine production and reveal a reciprocal regulatory role of JAK/STAT in TNFalpha-mediated senescence. PMID: 29176033
- our findings suggested that OSM suppresses SLUG expression and tumor metastasis of lung adenocarcinoma cells through inducing the inhibitory effect of the STAT1-dependent pathway and suppressing the activating effect of STAT3-dependent signaling PMID: 27486982
- miR-2909 could play a vital role in prostate carcinogenesis through modulation of ISGylation system and TGFbeta signalling via STAT1/SOCS3. PMID: 28622443
- The phosphorylation of STAT1 promotes its binding to TRADD, and thus recruits Fas-associated protein with DD (FADD) and caspase 8 to form DISC complexes. PMID: 28186502
- The results demonstrate that cystatin B interferes with the STAT-1 signaling and IFN-beta-antiviral responses perpetuating HIV in macrophage reservoirs. PMID: 27137788
- propose that one molecule of C protein associates with the STAT1:STAT2 heterodimer, inducing a conformational change to an antiparallel form, which is easily dephosphorylated PMID: 28978648
- Transfections of undifferentiated shed cells with miR-450a-5p or miR-28-5p mimics or with miR-450a-5p or miR-28-5p antagonists demonstrated that these miRNAs might play a role as posttranscriptional controllers of STAT1 mRNA during osteoblastic differentiation. PMID: 28407302
- Data indicate that dysregulated IFN-gamma secretion by NK cells contributed to a significant defect in STAT1 in patients with advanced melanoma in response to IL-2 stimulation. PMID: 27153543
- our results first identified that the proper increase of PD-1/STAT1 may contribute to hematopoietic improvement and prolonged survival in lower risk MDS. Our study proposed that the PD-1-related strategy to treat MDS should be different for lower risk patients than it is for those with highly progressive characteristics. PMID: 27686004
- findings shed new light on the STAT1/miR-181a/PTEN pathway in colorectal cancer and add new insight regarding the carcinogenesis of colorectal cancer. PMID: 28322462
- In lipotoxic hepatocytes, MLK3 activates a MAPK signaling cascade, resulting in the activating phosphorylation of STAT1, and CXCL10 transcriptional upregulation. PMID: 28262979
- Decreased phosphorylated STAT1 expression was accompanied by increased replication of hepatitis C virus and hepatitis E virus. PMID: 28442624
顯示更多
收起更多
-
相關疾病:Immunodeficiency 31B (IMD31B); Immunodeficiency 31A (IMD31A); Immunodeficiency 31C (IMD31C)
-
亞細胞定位:Cytoplasm. Nucleus.
-
蛋白家族:Transcription factor STAT family
-
數據庫鏈接:
Most popular with customers
-
YWHAB Recombinant Monoclonal Antibody
Applications: ELISA, WB, IHC, IF, FC
Species Reactivity: Human, Mouse, Rat
-
Phospho-YAP1 (S127) Recombinant Monoclonal Antibody
Applications: ELISA, WB, IHC
Species Reactivity: Human
-
-
-
-
-
-